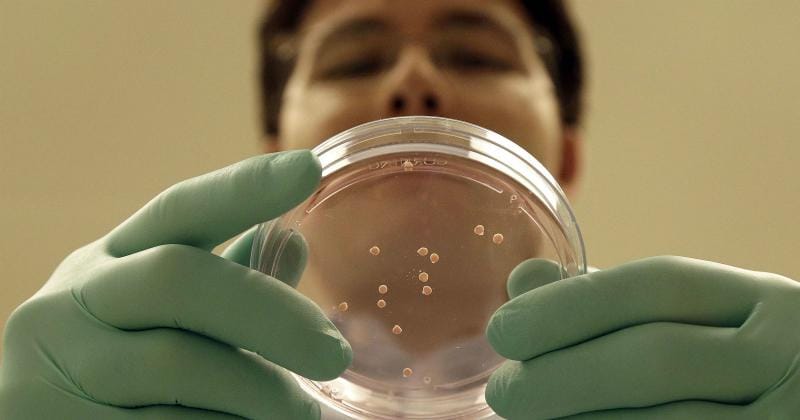
https://cdn.idntimes.com/content-images/post/20161222/oc2-71801c72e118d8247694b53b97b95be2.jpg

Wow! Wanita Ini Dapat Menciptakan Replika Otak Manusia

Satu-satunya cara untuk melihat otak manusia adalah membedah tulang tengkoraknya. Berkat kemajuan ilmu teknologi, manusia sekarang pun bisa menciptakan otak sendiri tanpa perlu membongkar tulang tengkorak. Sampel alias contoh otak manusia yang sudah dibuat dapat disaksikan di Cambridge, Inggris. Seorang ilmuwan bernama Madeline Lancaster membuat otak manusia dalam sebuah cawan.

Madeline Lancaster terobsesi pada otak manusia semenjak kecil. Sewaktu usia muda, ayahnya menunjukkan sebuah neuron yang tumbuh dalam cawan. Ayah Madeline sendiri merupakan seorang ilmuwan yang juga terkagum-kagum pada cara kerja otak manusia. Satu organ otak manusia berisi 100 milyar lebih sel-sel khusus yang disebut neuron. Sebanyak 100 milyar neuron saling terkoneksi satu sama lain dan menjadikan otak manusia sebagai salah satu objek yang paling rumit di alam semesta.

Berawal dari kekaguman itu yang kemudian membuat Madeline ingin mendalami studi mengenai otak manusia. Sayangnya, Madeline gak bisa mengamati sel otak manusia dalam kondisi hidup. Untuk mengatasi itu, ia membangun replika otak manusia dengan memanfaatkan sel induk yang dipanen dari sampel permukaan kulit. Sel-sel induk hasil panen itu kemudian direndam dalam nutrisi dan vitamin sampai berkembang menjadi sebuah neuron.
Neuron-neuron tersebut kemudian ditanam ke dalam gel protein padat. Neuron-neuron itu akan terus tumbuh dan mengorganisir dirinya secara otomatis seperti replika sebuah otak.
Keren banget kan ya?

















